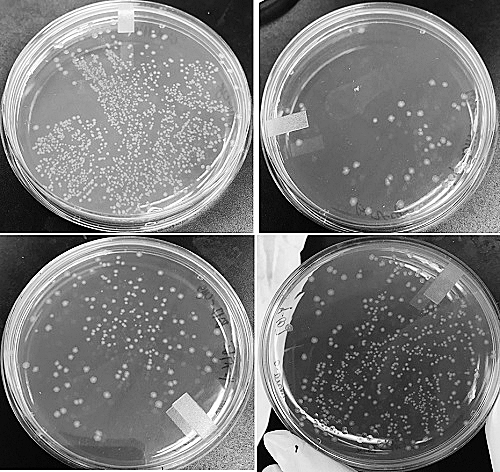
艰难梭菌感染诊断不再"艰难"

艰难梭菌图片

艰难梭菌感染
图片尺寸550x480
p> a target="_blank" href="/item/艰难梭菌/7844154" data-lemmaid
图片尺寸604x379
艰难梭菌(菌种)
图片尺寸690x518
研究揭示isoallolca 能抑制艰难梭菌生长
图片尺寸817x484
p> a target="_blank" href="/item/艰难梭菌/7844154" data-lemmaid
图片尺寸496x382
艰难梭菌
图片尺寸640x640
6 艰难梭菌(万古霉素):治疗艰难梭菌感染的首选先药物之一,也使菌体
图片尺寸600x600
梭状芽胞杆菌艰难梭菌的细菌
图片尺寸1280x853
艰难梭菌,也不算"难" - 临床检验 - 医学交流社区,分享临床经验,病例
图片尺寸694x533
艰难梭菌
图片尺寸612x408
艰难梭菌
图片尺寸1200x800
艰难梭菌感染诊断不再"艰难"
图片尺寸500x472
艰难梭菌感染会引起假膜性肠炎,导致腹泻,其有很强的复发性
图片尺寸1280x853
听菌说艰难梭菌一览致病机制和最新疗法
图片尺寸1280x718
艰难梭菌照片
图片尺寸612x550
研究发现超级细菌艰难梭菌可以在猪和人之间传播
图片尺寸700x540
艰难梭菌感染
图片尺寸711x593
digdissci免疫抑制剂的使用会增加艰难梭菌感染复发的风险
图片尺寸1100x734
研究估计致命的艰难梭菌感染传播
图片尺寸461x249
艰难梭菌
图片尺寸451x300